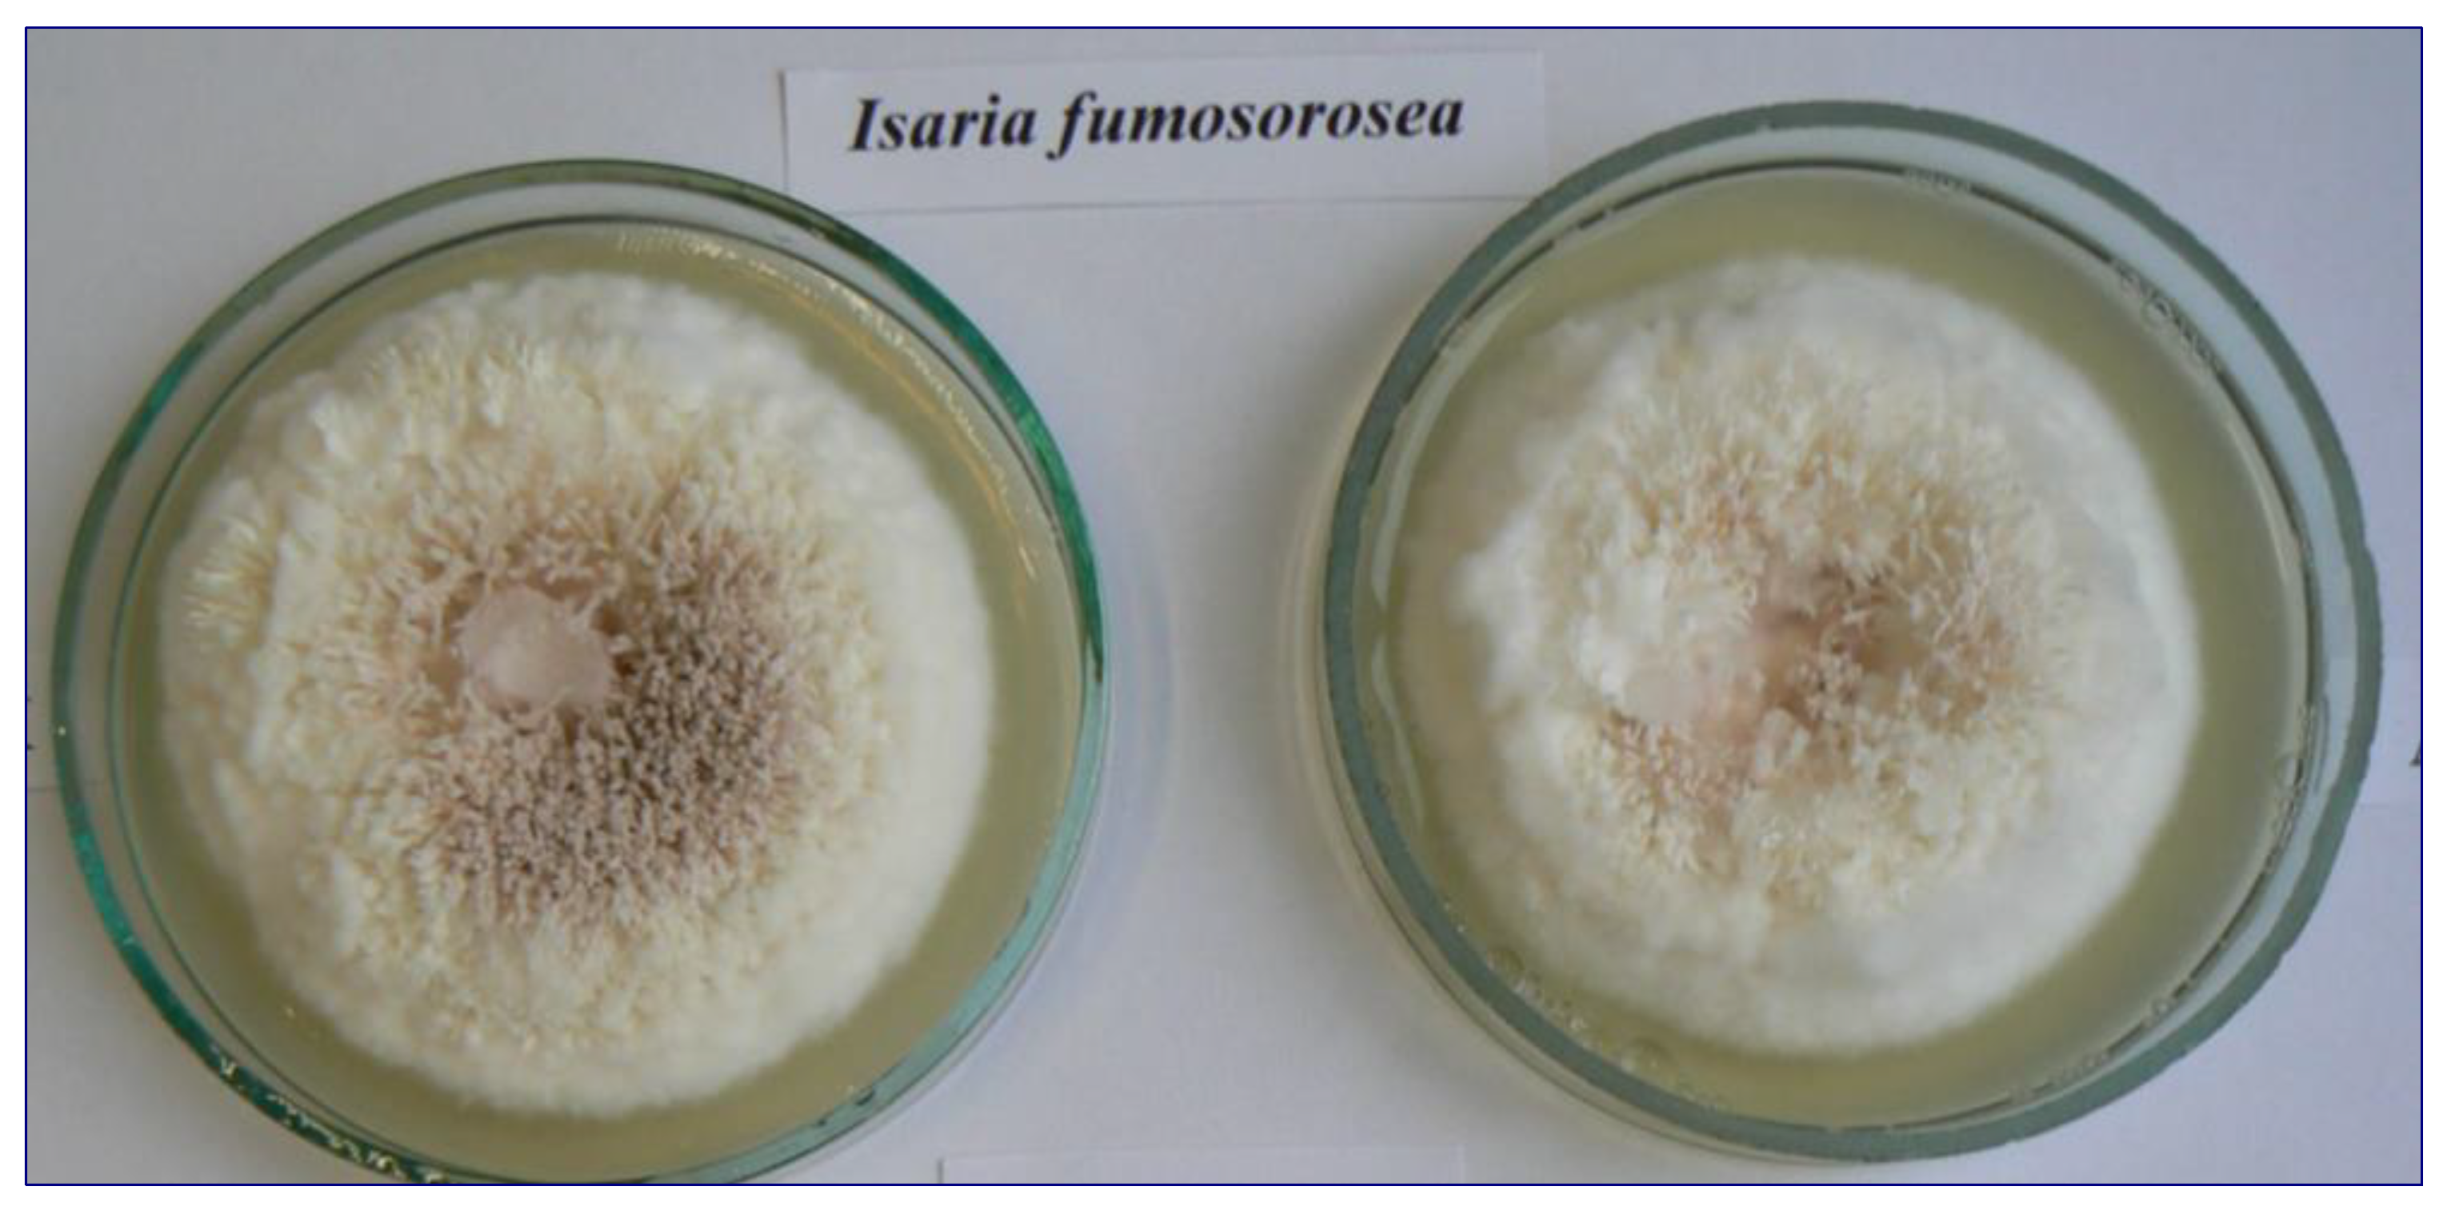
Animals 13 03782 g001

Effect of Selected Entomopathogenic Fungal Species on Embryonic Development of Ascaris suum (Nematoda)
Abstract
:Simple Summary
Abstract
1. Introduction
2. Materials and Methods
2.1. Fungi
2.2. Ascaris suum Eggs
2.3. Fungal Enzymatic Activity
2.4. Cytotoxicity of Entomopathogenic Fungi in MTT Assay
2.5. Statistical Analyses
3. Results
3.1. Influence of Entomopathogenic Fungi on the Embryonic Development of A. suum
3.2. The Enzymatic Activity of Entomopathogenic Fungi
3.3. Cytotoxicity of Entomopathogenic Fungi in MTT Test
4. Discussion
5. Conclusions
Author Contributions
Funding
Institutional Review Board Statement
Informed Consent Statement
Data Availability Statement
Acknowledgments
Conflicts of Interest
References
- Lindgren, K.; Gunnarsson, S.; Höglund, J.; Lindahl, C.; Roepstorff, A. Nematode parasite eggs in pasture soils and pigs on organic farms in Sweden. Org. Agric. 2020, 10, 289–300. [Google Scholar] [CrossRef]
- Zdybel, J.; Karamon, J.; Dąbrowska, J.; Różycki, M.; Bilska-Zając, E.; Kłapeć, T.; Cencek, T. Parasitological contamination with eggs Ascaris spp., Trichuris spp. and Toxocara spp. of dehydrated municipal sewage sludge in Poland. Environ. Pollut. 2019, 248, 621–626. [Google Scholar] [CrossRef] [PubMed]
- Miller, L.A.; Colby, K.; Manning, S.E.; Hoenig, D.; McEvoy, E.; Montgomery, S.; Mathison, B.; de Almeida, M.; Bishop, H.; Dasilva, A.; et al. Ascariasis in humans and pigs on small-scale farms, Maine, USA, 2010–2013. Emerg. Infect. Dis. 2015, 21, 332–334. [Google Scholar] [CrossRef] [PubMed]
- WHO. Integrated Guide to Sanitary Parasitology; Regional Office for the Eastern Mediterranean Regional Centre for Environmental Health Activities Amman: Amman, Jordan, 2004; ISBN 92-9021-386-8. [Google Scholar]
- Amin, O.M. Pathogenic micro-organisms and helminths in sewage products, Arabian Gulf, country of Bahrain. Am. J. Public Health 1988, 78, 314–315. [Google Scholar] [CrossRef] [PubMed]
- Brownell, S.A.; Nelson, K.L. Inactivation of single-celled Ascaris suum eggs by low-pressure UV radiation. Appl. Environ. Microbiol. 2006, 72, 2178–2184. [Google Scholar] [CrossRef]
- Nosal, P. Prevention and applied methods of worm control in pigs. Przegl. Hod. 1996, 2, 11–13. [Google Scholar]
- Knecht, D.; Popiołek, M.; Zaleśny, G. Does meatiness of pigs depend on the level of gastro-intestinal parasites infection? Prev. Vet. Med. 2011, 99, 234–239. [Google Scholar] [CrossRef]
- Dadas, S.; Mishra, S.K.; Jawalagatti, V.; Gupta, S.; Gudewar, J.; Scholar, M.D. Prevalence of Gastro-Intestinal Parasites in Pigs (Sus scrofa) of Mumbai Region. Int. J. Sci. Environ. Technol. 2016, 5, 822–826. [Google Scholar]
- Katakam, K.K.; Thamsborg, S.M.; Dalsgaard, A.; Kyvsgaard, N.C.; Mejer, H. Environmental contamination and transmission of Ascaris suum in Danish organic pig farms. Parasit. Vectors 2016, 9, 80. [Google Scholar] [CrossRef]
- Nwafor, I.C.; Roberts, H.; Fourie, P. Prevalence of gastrointestinal helminths and parasites in smallholder pigs reared in the central Free State Province. Onderstepoort J. Vet. Res. 2019, 86, e1–e8. [Google Scholar] [CrossRef]
- Knecht, D.; Jankowska, A.; Zaleśny, G. The impact of gastrointestinal parasites infection on slaughter efficiency in pigs. Vet. Parasitol. 2012, 184, 291–297. [Google Scholar] [CrossRef] [PubMed]
- Tomass, Z.; Imam, E.; Kifleyohannes, T.; Tekle, Y.; Weldu, K. Prevalence of gastrointestinal parasites and Cryptosporidium species in extensively managed pigs in Mekelle and urban areas of southern zone of Tigray region, northern Ethiopia. Vet. World 2013, 6, 433–439. [Google Scholar] [CrossRef]
- Nejsum, P.; Betson, M.; Bendall, R.P.; Thamsborg, S.M.; Stothard, J.R. Assessing the zoonotic potential of Ascaris suum and Trichuris suis: Looking to the future from an analysis of the past. J. Helminthol. 2012, 86, 148–155. [Google Scholar] [CrossRef] [PubMed]
- Roepstorff, A.; Nansen, P. Epidemiology and control of helminth infections in pigs under intensive and non-intensive production systems. Vet. Parasitol. 1994, 54, 69–85. [Google Scholar] [CrossRef]
- Nejsum, P.; Parker, E.D.J.; Frydenberg, J.; Roepstorff, A.; Boes, J.; Haque, R.; Astrup, I.; Prag, J.; Skov Sørensen, U.B. Ascariasis is a zoonosis in Denmark. J. Clin. Microbiol. 2005, 43, 1142–1148. [Google Scholar] [CrossRef]
- Peng, W.; Criscione, C.D. Ascariasis in people and pigs: New inferences from DNA analysis of worm populations. Infect. Genet. Evol. J. Mol. Epidemiol. Evol. Genet. Infect. Dis. 2012, 12, 227–235. [Google Scholar] [CrossRef]
- Stewart, T.B. Economics of endoparasitism in pigs. Pig News Inf. 2001, 22, 29–30. [Google Scholar]
- Monteiro, K.J.L.; Calegar, D.A.; Santos, J.P.; Bacelar, P.A.A.; Coronato-Nunes, B.; Reis, E.R.C.; Boia, M.N.; Carvalho-Costa, F.A.; Jaeger, L.H. Genetic diversity of Ascaris spp. infecting humans and pigs in distinct Brazilian regions, as revealed by mitochondrial DNA. PLoS ONE 2019, 14, e0218867. [Google Scholar] [CrossRef]
- Leles, D.; Gardner, S.L.; Reinhard, K.; Iñiguez, A.; Araujo, A. Are Ascaris lumbricoides and Ascaris suum a single species? Parasit. Vectors 2012, 5, 42. [Google Scholar] [CrossRef]
- da Silva Alves, E.B.; Conceição, M.J.; Leles, D. Ascaris lumbricoides, Ascaris suum, or “Ascaris lumbrisuum”? J. Infect. Dis. 2016, 213, 1355. [Google Scholar]
- Søe, M.J.; Kapel, C.M.O.; Nejsum, P. Ascaris from Humans and Pigs Appear to Be Reproductively Isolated Species. PLoS Negl. Trop. Dis. 2016, 10, e0004855. [Google Scholar] [CrossRef] [PubMed]
- Papajová, I.; Szabová, E.; Juriš, P.; Oláhová, K. Asanation of the environment contaminated with enteronematode eggs. Folia Vet. 2005, 49, 40–42. [Google Scholar]
- Garcia-Bustos, J.F.; Sleebs, B.E.; Gasser, R.B. An appraisal of natural products active against parasitic nematodes of animals. Parasit. Vectors 2019, 12, 306. [Google Scholar] [CrossRef]
- Mustafa, U.; Kaur, G. Extracellular enzyme production in Metarhizium anisopliae isolates. Folia Microbiol. 2009, 54, 499–504. [Google Scholar] [CrossRef]
- Schrank, A.; Vainstein, M.H. Metarhizium anisopliae enzymes and toxins. Toxicon 2010, 56, 1267–1274. [Google Scholar] [CrossRef] [PubMed]
- Wieloch, W. Toxic metabolites produced by the parasitic fungus Conidiobolus coronatus. Wiad. Parasitol. 2007, 53, 355–357. [Google Scholar]
- Sánchez-Pérez, L.; Barranco-Florido, J.; Rodríguez-Navarro, S.; Cervantes-Mayagoitia, J.; Ramos-López, M. Enzymes of entomopathogenic fungi, advances and insights. Adv. Enzym. Res. 2014, 2, 65–76. [Google Scholar] [CrossRef]
- Silva, A.R.; Araújo, J.V.; Braga, F.R.; Alves, C.D.F.; Frassy, L.N. In vitro ovicidal activity of the nematophagous fungi Duddingtonia flagrans, Monacrosporium thaumasium and Pochonia chlamydosporia on Trichuris vulpis eggs. Vet. Parasitol. 2010, 172, 76–79. [Google Scholar] [CrossRef]
- Braga, F.R.; Ferreira, S.R.; Araújo, J.V.; Araujo, J.M.; Silva, A.R.; Carvalho, R.O.; Campos, A.K.; Freitas, L.G. Predatory activity of Pochonia chlamydosporia fungus on Toxocara (syn. Neoascaris) vitulorum eggs. Trop. Anim. Health Prod. 2010, 42, 309–314. [Google Scholar] [CrossRef]
- Araújo, J.V.; Braga, F.R.; Silva, A.R.; Araujo, J.M.; Tavela, A.O. In vitro evaluation of the effect of the nematophagous fungi Duddingtonia flagrans, Monacrosporium sinense, and Pochonia chlamydosporia on Ascaris suum eggs. Parasitol. Res. 2008, 102, 787–790. [Google Scholar] [CrossRef]
- Araújo, J.M.; Araújo, J.V.; Braga, F.R.; Carvalho, R.O.; Silva, A.R.; Campos, A.K. Interaction and ovicidal activity of nematophagous fungus Pochonia chlamydosporia on Taenia saginata eggs. Exp. Parasitol. 2009, 121, 338–341. [Google Scholar] [CrossRef] [PubMed]
- Braga, F.R.; Araújo, J.V.; Campos, A.K.; Silva, A.R.; Araújo, J.M.; Carvalho, R.O.; Corrĕa, D.N.; Pereira, C.A.J. In vitro evaluation of the effect of the nematophagous fungi Duddingtonia fragrans, Manacrosporium sinense and Pochonia chlamydo-sporia on Schistosoma mansoni eggs. World J. Microbiol. Biotechnol. 2008, 24, 2713–2716. [Google Scholar] [CrossRef]
- Braga, F.R.; Araújo, J.V.; Campos, A.K.; Araújo, J.M.; Carvalho, R.O.; Silva, A.R.; Tavela, A.O. In vitro evaluation on the action of the nematophagous fungi Duddingtonia fragrans, Manacrosporium sinense and Pochonia chlamydosporia on Fasciola hepatica eggs. World J. Microbiol. Biotechnol. 2008, 24, 1559–1564. [Google Scholar] [CrossRef]
- Blaszkowska, J.; Kurnatowski, P.; Wojcik, A.; Goralska, K.; Szwabe, K. In vitro evaluation of the ovistatic and ovicidal effect of the cosmopolitan filamentous fungi isolated from soil on Ascaris suum eggs. Vet. Parasitol. 2014, 199, 165–171. [Google Scholar] [CrossRef]
- Jaborowska, M. Limitation in the population of parasitic geohelminths by saprotrophic soil fungi and their secretions. Ann. Acad. Med. Stetin. 2006, 52, 37–46. [Google Scholar]
- Jaborowska, M.; Kuźna-Grygiel, W.; Mazurkiewicz-Zapałowicz, K.; Kołodziejczyk, L. Comparative sudies on the antagonistic effects of mould fungi on the embryogenesis of Ascaris suum. Adv. Agric. Sci. 2006, 10, 45–49. [Google Scholar]
- Basualdo, J.A.; Ciarmela, M.L.; Sarmiento, P.L.; Minvielle, M.C. Biological activity of Paecilomyces genus against Toxocara canis eggs. Parasitol. Res. 2000, 86, 854–859. [Google Scholar] [CrossRef]
- Ciarmela, M.L.; Minvielle, M.C.; Lori, G.; Basualdo, J.A. Biological interaction between soil fungi and Toxocara canis eggs. Vet. Parasitol. 2002, 103, 251–257. [Google Scholar] [CrossRef]
- Lýsek, H.; Krajcí, D. Penetration of ovicidal fungus Verticillium chlamydosporium through the Ascaris lumbricoides egg-shells. Folia Parasitol. 1987, 34, 57–60. [Google Scholar]
- Lýsek, H.; Stĕrba, J. Colonization of Ascaris lumbricoides eggs by the fungus Verticillium chlamydosporium Goddard. Folia Parasitol. 1991, 38, 255–259. [Google Scholar]
- Zimmermann, G. The ‘Galleria bait method’ for detection of entomopathogenic fungi in soil. J. Appl. Entomol. 1986, 102, 213–215. [Google Scholar] [CrossRef]
- Strasser, H.; Forer, A.; Schinner, F. Development of media for the selective isolation and maintenance of viruIence of Beauveria brongniartii. In Proceedings of the 3rd International Workshop on Microbial Control of Soil Dwerling Pests, Lincoln, New Zealand, 21–23 February 1996. [Google Scholar]
- Kołodziejczyk, L.; Mazurkiewicz-Zapałowicz, K.; Janda, K.; Dzika, E. The effect of saprotrophic fungi on the development and hatching of Fasciola hepatica eggs. Folia Biol. 2014, 62, 149–154. [Google Scholar] [CrossRef] [PubMed]
- Kołodziejczyk, L.; Mazurkiewicz-Zapałowicz, K.; Twaruzek, M.; Grajewski, J.; Łopusiewicz, Ł.; Rybińska, A.; Dzika, E.; Pilarczyk, B. The ovistatic effect of saprotrophic soil fungi on Ascaris suum eggs. Folia Biol. 2019, 67, 109–118. [Google Scholar] [CrossRef]
- Blaszkowska, J.; Wojcik, A.; Kurnatowski, P.; Szwabe, K. Biological interactions between soil saprotrophic fungi and Ascaris suum eggs. Vet. Parasitol. 2013, 196, 401–408. [Google Scholar] [CrossRef] [PubMed]
- Araújo, J.V.; Santos, M.A.; Ferraz, S. Ovicidal effect of nematophagous fungi on embryonate eggs of Toxocara canis. Arq. Bras. Med. Vet. Zootec. 1995, 47, 37–42. (In Portuguese) [Google Scholar]
- Hanelt, M.; Gareis, M.; Kollarczik, B. Cytotoxicity of mycotoxins evaluated by the MTT-cell culture assay. Mycopathologia 1994, 128, 167–174. [Google Scholar] [CrossRef]
- Masamha, B.; Gadzirayi, C.T.; Mukutirwa, I. Efficacy of Allium sativum (garlic) in controlling nematode parasites in sheep. Int. J. Appl. Res. Vet. Med. 2010, 8, 161–169. [Google Scholar]
- Burke, J.M.; Wells, A.; Casey, P.; Miller, J.E. Garlic and papaya lack control over gastrointestinal nematodes in goats and lambs. Vet. Parasitol. 2009, 159, 171–174. [Google Scholar] [CrossRef]
- El Shenawy, N.S.; Soliman, M.F.M.; Reyad, S.I. The effect of antioxidant properties of aqueous garlic extract and Nigella sativa as anti-schistosomiasis agents in mice. Rev. Inst. Med. Trop. Sao Paulo 2008, 50, 29–36. [Google Scholar] [CrossRef]
- Costa, C.T.C.; Bevilaqua, C.M.L.; Camurça-Vasconcelos, A.L.F.; Maciel, M.V.; Morais, S.M.; Castro, C.M.S.; Braga, R.R.; Oliveira, L.M.B. In vitro ovicidal and larvicidal activity of Azadirachta indica extracts on Haemonchus contortus. Small Rumin. Res. 2008, 74, 284–287. [Google Scholar] [CrossRef]
- Feitosa, T.F.; Vilela, V.L.R.; Athayde, A.C.R.; Braga, F.R.; Dantas, E.S.; Vieira, V.D.; de Melo, L.R.B. Anthelmintic efficacy of pumpkin seed (Cucurbita pepo Linnaeus, 1753) on ostrich gastrointestinal nematodes in a semiarid region of Paraíba State, Brazil. Trop. Anim. Health Prod. 2013, 45, 123–127. [Google Scholar] [CrossRef] [PubMed]
- Giarratana, F.; Muscolino, D.; Beninati, C.; Giuffrida, A.; Panebianco, A. Activity of Thymus vulgaris essential oil against Anisakis larvae. Exp. Parasitol. 2014, 142, 7–10. [Google Scholar] [CrossRef] [PubMed]
- Khan, S.; Nadir, S.; Lihua, G.; Xu, J.; Holmes, K.A.; Dewen, Q. Identification and characterization of an insect toxin protein, Bb70p, from the entomopathogenic fungus, Beauveria bassiana, using Galleria mellonella as a model system. J. Invertebr. Pathol. 2016, 133, 87–94. [Google Scholar] [CrossRef] [PubMed]
- Yang, J.; Huang, X.; Tian, B.; Sun, H.; Duan, J.; Wu, W.; Zhang, K. Characterization of an extracellular serine protease gene from the nematophagous fungus Lecanicillium psalliotae. Biotechnol. Lett. 2005, 27, 1329–1334. [Google Scholar] [CrossRef]
- Fromentin, H. Enzymatic characterization with the API ZYM system of entomophthorales potentially pathogenic to man. Curr. Microbiol. 1982, 7, 315–318. [Google Scholar] [CrossRef]
- Castellanos-Moguel, J.; González-Barajas, M.; Mier, T.; Reyes-Montes, M.D.R.; Aranda, E.; Toriello, C. Virulence testing and extracellular subtilisin-like (Pr1) and trypsin-like (Pr2) activity during propagule production of Paecilomyces fumosoroseus isolates from whiteflies (Homoptera: Aleyrodidae). Rev. Iberoam. Micol. 2007, 24, 62–68. [Google Scholar] [CrossRef]
- Mishra, S.; Kumar, P.; Malik, A. Effect of process parameters on the enzyme activity of a novel Beauveria bassiana isolate. Int. J. Curr. Microbiol. App. Sci. 2013, 2, 49–56. [Google Scholar]
- Kaur, G.; Padmaja, V. Relationships among activities of extracellular enzyme production and virulence against Helicoverpa armigera in Beauveria bassiana. J. Basic Microbiol. 2009, 49, 264–274. [Google Scholar] [CrossRef]
- Fernandes, E.G.; Valério, H.M.; Feltrin, T.; Van Der Sand, S.T. Variability in the production of extracellular enzymes by entomopathogenic fungi grown on different substrates. Braz. J. Microbiol. 2012, 43, 827–833. [Google Scholar] [CrossRef]
- Fernandes, E.K.K.; Moraes, A.M.L.; Pacheco, R.S.; Rangel, D.E.N.; Miller, M.P.; Bittencourt, V.R.E.P.; Roberts, D.W. Genetic diversity among Brazilian isolates of Beauveria bassiana: Comparisons with non-Brazilian isolates and other Beauveria species. J. Appl. Microbiol. 2009, 107, 760–774. [Google Scholar] [CrossRef]
- Ali, S.; Huang, Z.; Ren, S. Production of cuticle degrading enzymes by Isaria fumosorosea and their evaluation as a biocontrol agent against diamondback moth. J. Pest Sci. 2010, 83, 361–370. [Google Scholar] [CrossRef]
- Włóka, E. Characterization of proteo-, chitino- and lipolytic enzymes of parasitic fungus Conidiobolus coronatus. Wiad. Parazytol. 2010, 56, 83–85. [Google Scholar] [PubMed]
- Bridge, P.D.; Williams, M.A.J.; Prior, C.; Paterson, R.R.M. Morphological, biochemical and molecular characteristics of Metarhizium anisopliae and M. flavoviride. J. Gen. Microbiol. 1993, 139, 1163–1169. [Google Scholar] [CrossRef]

| Enzyme | Beauveria bassiana | Beauveria brongniartii | Conidiobolus coronatus | Isaria fumosorosea | Metarhizium robertsii | |
|---|---|---|---|---|---|---|
| 1 | Control | 0 | 0 | 0 | 0 | 0 |
| 2 | Alkaline phosphatase | 1 | 1 | 3 | 3 | 0 |
| 3 | Esterase (C4) | 3 | 1 | 3 | 3 | 3 |
| 4 | Esterase lipase (C8) | 1 | 1 | 3 | 3 | 0 |
| 5 | Lipase (C14) | 0 | 0 | 0 | 0 | 0 |
| 6 | Leucine arylamidase | 3 | 1 | 3 | 3 | 3 |
| 7 | Valine arylamidase | 0 | 0 | 2 | 3 | 0 |
| 8 | Cystine arylamidase | 0 | 1 | 2 | 3 | 0 |
| 9 | Trypsin | 0 | 0 | 0 | 3 | 0 |
| 10 | Chymotrypsin | 0 | 0 | 0 | 1 | 0 |
| 11 | Acid phosphatase | 5 | 5 | 5 | 5 | 5 |
| 12 | Naphtol-AS-BI-phosphohydrolase | 3 | 5 | 5 | 5 | 5 |
| 13 | α-galactosidase | 0 | 0 | 0 | 0 | 0 |
| 14 | β-galactosidase | 1 | 3 | 2 | 5 | 0 |
| 15 | β-glucuronidase | 0 | 0 | 0 | 1 | 0 |
| 16 | α-glucosidase | 0 | 0 | 0 | 5 | 0 |
| 17 | β-glucosidase | 5 | 5 | 5 | 5 | 3 |
| 18 | N-acetyl-β-glucosaminidase | 3 | 5 | 5 | 4 | 5 |
| 19 | α-mannosidase | 0 | 0 | 0 | 0 | 0 |
| 20 | α-fucosidase | 1 | 1 | 1 | 0 | 0 |
| No | Entomopathogenic Fungi | Step | IC50 (cm2/mL) | Degree of Cytotoxicity |
|---|---|---|---|---|
| 1 | Control PDA | 2 | 15.625 | + |
| 2 | Control cells | - | - | - |
| 3 | Beauveria bassiana | 1 | 31.25 | + |
| 4 | Beauveria brongniartii | 1 | 31.25 | + |
| 5 | Conidiobolus coronatus | 2 | 15.625 | + |
| 6 | Isaria fumosorosea | 3 | 7.813 | + |
| 7 | Metarhizium robertsii | 4 | 3.906 | ++ |
Disclaimer/Publisher’s Note: The statements, opinions and data contained in all publications are solely those of the individual author(s) and contributor(s) and not of MDPI and/or the editor(s). MDPI and/or the editor(s) disclaim responsibility for any injury to people or property resulting from any ideas, methods, instructions or products referred to in the content. |
© 2023 by the authors. Licensee MDPI, Basel, Switzerland. This article is an open access article distributed under the terms and conditions of the Creative Commons Attribution (CC BY) license (https://creativecommons.org/licenses/by/4.0/).
Share and Cite
Mazurkiewicz-Zapałowicz, K.; Pilarczyk, B.; Kołodziejczyk, L.; Tkaczuk, C.; Twarużek, M.; Łopusiewicz, Ł.; Grajewski, J.; Dzika, E.; Kalisińska, E. Effect of Selected Entomopathogenic Fungal Species on Embryonic Development of Ascaris suum (Nematoda). Animals 2023, 13, 3782. https://doi.org/10.3390/ani13243782
Mazurkiewicz-Zapałowicz K, Pilarczyk B, Kołodziejczyk L, Tkaczuk C, Twarużek M, Łopusiewicz Ł, Grajewski J, Dzika E, Kalisińska E. Effect of Selected Entomopathogenic Fungal Species on Embryonic Development of Ascaris suum (Nematoda). Animals. 2023; 13(24):3782. https://doi.org/10.3390/ani13243782
Chicago/Turabian StyleMazurkiewicz-Zapałowicz, Kinga, Bogumiła Pilarczyk, Lidia Kołodziejczyk, Cezary Tkaczuk, Magdalena Twarużek, Łukasz Łopusiewicz, Jan Grajewski, Ewa Dzika, and Elżbieta Kalisińska. 2023. "Effect of Selected Entomopathogenic Fungal Species on Embryonic Development of Ascaris suum (Nematoda)" Animals 13, no. 24: 3782. https://doi.org/10.3390/ani13243782
APA StyleMazurkiewicz-Zapałowicz, K., Pilarczyk, B., Kołodziejczyk, L., Tkaczuk, C., Twarużek, M., Łopusiewicz, Ł., Grajewski, J., Dzika, E., & Kalisińska, E. (2023). Effect of Selected Entomopathogenic Fungal Species on Embryonic Development of Ascaris suum (Nematoda). Animals, 13(24), 3782. https://doi.org/10.3390/ani13243782

